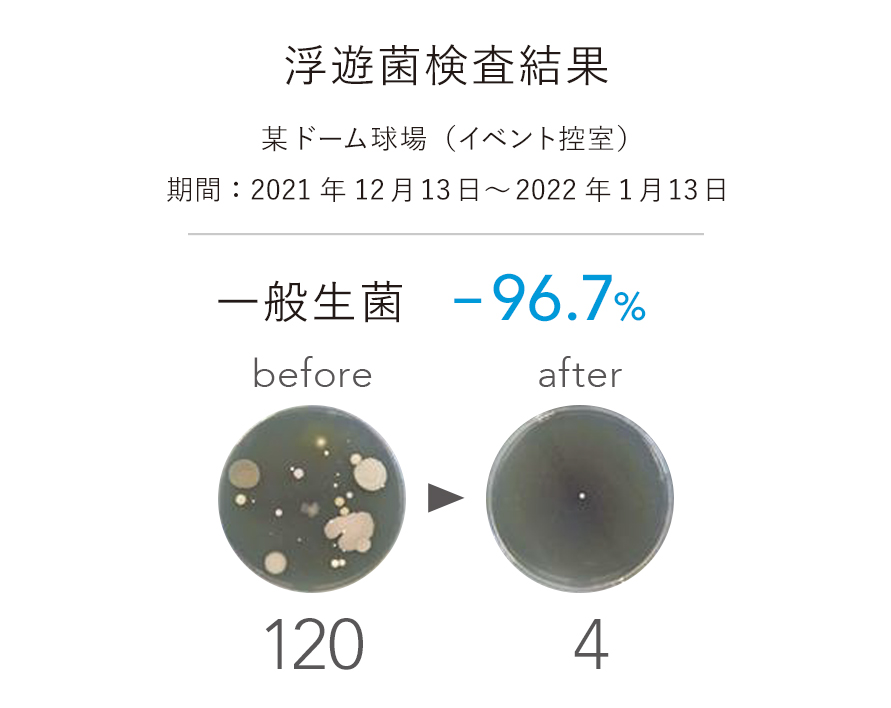
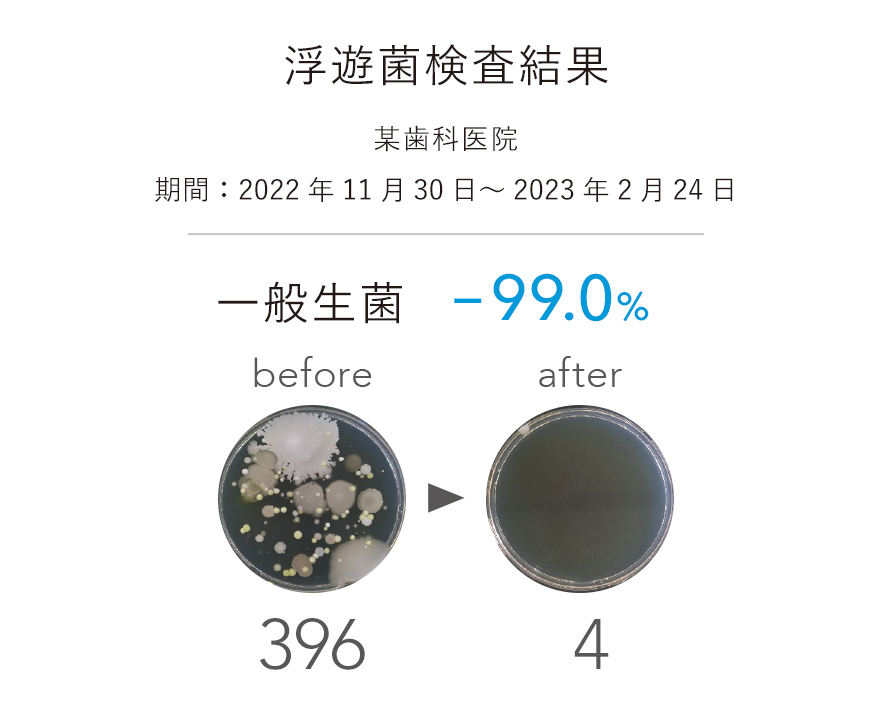
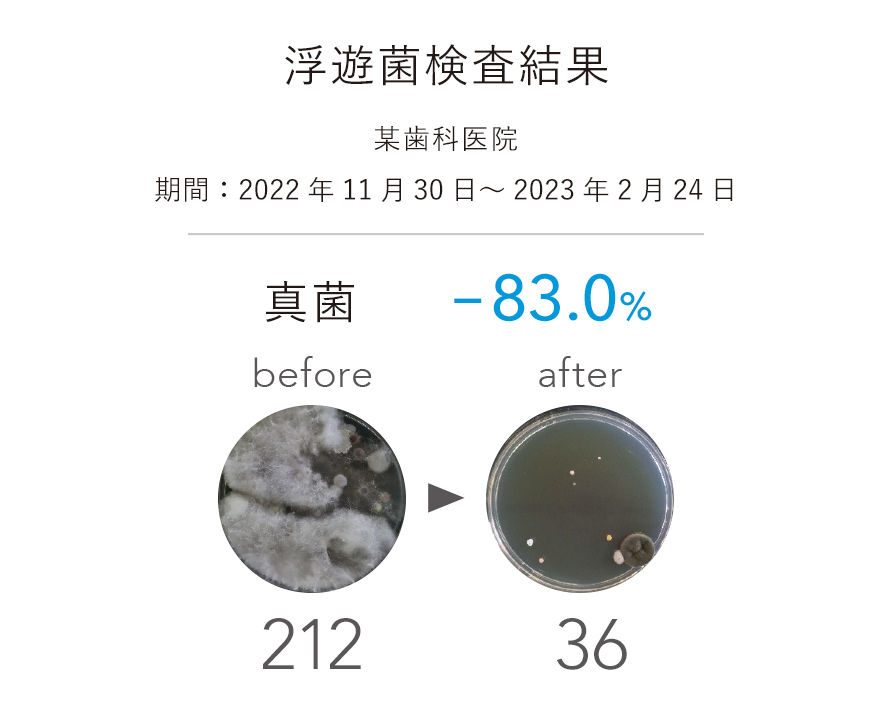

PRODUCT GUIDE

-
- 空調機がなく、天井設置も困難な場合
- AIRSCRI bespoke
- 循環型床置きタイプの空気清浄装置
- 卓越したUVC性能&パワーで究極の空気清浄力を発揮
有害物質を瞬時にDNAから破壊し、死滅・生存不可能に!
- 世界屈指の殺菌照射性能を持つステリルエアー®のUVCランプ搭載
- 0.3秒でSARS・コロナウイルスを99.9%除去可能
- メンテナンスフリー:1年に1回のランプを交換するだけ
※装置内のUVC照射強度は、6,200~11,000μW/c㎡
処理空間量*:100〜150㎥/h
適用床面積:〜55㎡(約30畳)* 1〜2時間に処理可能な空間の目安

UVCエアステリライザーは、不活化するために最適なUVC波長253.7nmで生物因子 (植物系含む) の微生物や菌細胞のDNA構造を破壊し、複製/増殖/生存不可能にします。浮遊菌やホコリに潜む微生物など、あらゆる有害物質を死滅させます。
乱反射構造によって通常の3倍《10,000 W/c㎡》以上の照射強度を発揮、圧倒的な殺菌能力で効果的に除菌し、気になるニオイも元から消臭。24時間365日稼働しても、空気除菌に必要な照射強度を保つため、最強の空気清浄機能を維持し続けます。
本製品は、循環タイプの機器なため活用時間が長いほど効力を発揮。稼働を継続させることにより菌の減少を促進し、食品工場としてトップクラスの空間づくりができます。
RESULT
導入済みの企業では
続々と成果をあげています
※換算値を「1㎥」あたりの値に変換した値(個/㎥)
※単位cfu/㎥
検査機関:日本微生物クリニック株式会社/(ステリライザー設置前)赤門ウイレックス株式会社
CONTACT
お問い合わせ・お申し込み
各製品へのお問い合わせ、お申し込み、ご相談等はこちらのフォームからお気軽にご相談ください。
内容を確認次第担当者よりご連絡させていただきます。
© 2026 株式会社 中部テクノ